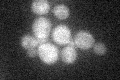
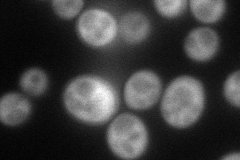
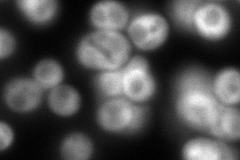
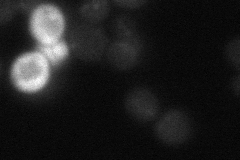
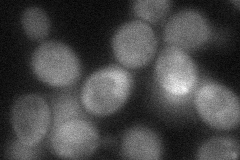

View description
Carnitine acetyltransferase; has similarity to Yat1p, which is a carnitine acetyltransferase associated with the mitochondrial outer membrane
Localization:
Intensity:
Fold change:
Significance:
-
C’ GFP library in SD
cytosol23.77 -
N' NOP1pr-GFP in SD
cytosol94.8006 -
N' TEF2pr-mCherry in SD
cytosol365.301 -
N' NATIVEpr-GFP in SD
cytosol20.6874 -
N' TEF2pr-VC and Cyto-VN in SD
cytosol42.4132 -
C’ GFP library in SD+DTT

cytosol26.541.11No -
C’ GFP library in SD+H2O2

cytosol28.681.2No -
C’ GFP library in Starvation Media

cytosol18.280.76No -
C’ GFP library on the background of Pup2-DaMP

cytosol -
C’ GFP library on the background of CCT mutant

cytosol20.18950.84905No
